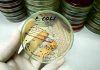
Da salmonella a listeria a E.Coli, ipotesi in campo in tossinfezioni alimentari

(Adnkronos) –
Botta e risposta, sui social, fra il virologo Roberto Burioni e il papà di Nicola, bimbo ‘fragile’ che ha contratto la varicella ed è stato ricoverato in terapia sub-intensiva. Il piccolo non era vaccinato contro questa malattia: il padre Thomas Guidotti è infatti un free-vax, convinto che l’encefalopatia di cui è affetto il figlio sia stata causata dalla vaccinazione esavalente nei primi mesi di vita. Da allora non lo ha sottoposto ad altre vaccinazioni ed è diventato un attivista contro i vaccini.
“Purtroppo in pazienti così fragili la varicella può avere un decorso grave, e pare che così sia stato: il bambino ha sviluppato una polmonite ed è stato molto male – scriveva Burioni, su Facebook, alla notizia del ricovero di Nicola in terapia sub-intensiva – Prima di tutto facciamo i migliori auguri di guarigione completa e veloce a Nicola e mandiamo un abbraccio affettuoso al padre Thomas e a tutta la sua famiglia: di fronte alla malattia non può esserci che l’affetto e la solidarietà e l’augurio più sincero. Però cogliamo l’occasione per ricordare che con la salute non si scherza. Le conseguenze di decisioni ideologiche che rifiutano di prendere in considerazione la realtà delle cose possono essere molto gravi”. Dopo giorni di apprensione, le condizioni del bimbo migliorano. Può lasciare la terapia sub-intensiva, continuerà le sue terapie e la fisioterapia polmonare in reparto.
“Buone notizie che ci riempiono di gioia – commenta Burioni – Però adesso, caro Thomas, finiscila di stare dietro alle scemenze e vaccinalo con tutti i vaccini consigliati, perché fare rischiare la vita a Nicola per le tue superstizioni antiscienfiche non mi pare il caso. Se con la varicella è successo questo, con il morbillo non se la cava. Dammi retta”. “Ringrazio il portavoce degli ipocriti per la vicinanza e la solidarietà”, è la risposta di papà Thomas, che poi liquida Burioni con sarcasmo: “Dopo i suoi post la Gsk ci ha chiamati per essere i protagonisti del nuovo vaccino contro la varicella dove interpreteremo la parte dei Novax pentiti. Il ricavato verrà donato al recupero dei medici che da piccoli sono caduti dal seggiolone”, chiosa postando la sua foto nell’atto di brindare con in mano una tazza rossa su cui campeggia la scritta ‘novax’. “Lo scherno di Ghidotti non mi tocca – replica il virologo – ma chi pensa al piccolo Nicola?”.
“Pensando a quel povero sfortunatissimo bambino lasciato da solo dal nostro Stato che dovrebbe proteggere i più deboli e a quello che rischia Nicola nel presente e nel futuro – senza nessuno a difenderlo in questo mondo dove chi dà un calcio a un cane finisce (giustamente) in tribunale – mi passa la voglia di scherzare – scrive Burioni su Facebook – Tutti combattiamo giustamente per i diritti dei lavoratori, delle donne, delle minoranze, anche per quelli degli animali. Ma ai diritti di un bambino indifeso, gravemente malato e immensamente vulnerabile – oggi, in Italia, nel 2024 – chi ci pensa?”.